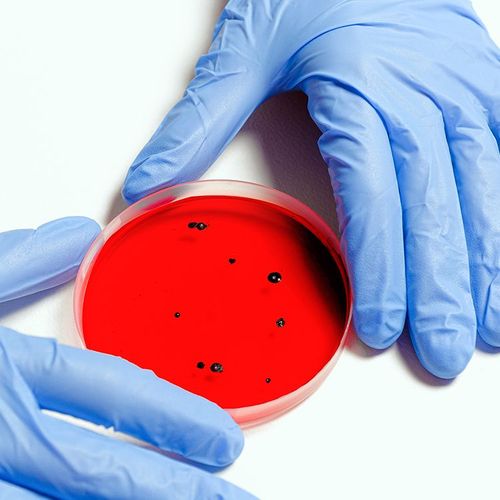
Breakthrough Research Uses Viruses to Cure Diabetes

Breakthrough Research Uses Viruses to Cure Diabetes
We're accustomed to thinking of viruses as "bad guys" that the world would be better without—but now that scientists have used a virus to transform a non-insulin-producing pancreatic cell into one that produced insulin, we...












